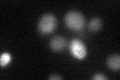

View description
Mitochondrial aldehyde dehydrogenase, required for growth on ethanol and conversion of acetaldehyde to acetate; phosphorylated; activity is K+ dependent; utilizes NADP+ or NAD+ equally as coenzymes; expression is glucose repressed
Localization:
Intensity:
Fold change:
Significance:
-
C’ GFP library in SD

below threshold15.96 -
N' NOP1pr-GFP in SD

mitochondria114.443 -
N' TEF2pr-mCherry in SD

mitochondria164.342 -
N' NATIVEpr-GFP in SD

mitochondria33.8066 -
N' TEF2pr-VC and Cyto-VN in SD

#N/A0 -
C’ GFP library in SD+DTT
cytosol18.761.17No -
C’ GFP library in SD+H2O2

cytosol19.551.22No -
C’ GFP library in Starvation Media

cytosol20.181.26No -
C’ GFP library on the background of Pup2-DaMP

below threshold -
C’ GFP library on the background of CCT mutant

below threshold16.47171.03164No
